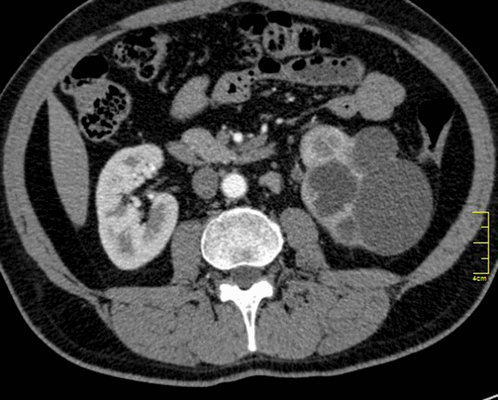
Туберкулез почки

Рентгенограмма, КТ, МРТ при туберкулезе костей и суставов
Добавил пользователь Morpheus Обновлено: 22.01.2026
Магнитно-резонансная томография часто используется как средство для диагностики туберкулеза. Своевременное выявление такой болезни имеет решающее значение в успешности ее лечения.
Первоначально при подозрении на туберкулез пациента отправляют делать рентген. Далее может использоваться магнитно-резонансная или компьютерная форма томографии. Они позволяют точно установить расположение очага патологии, оценить степень развития и опасности воспалительного процесса.
Многие врачи отмечают, что именно применение МРТ и КТ сегодня позволят получить наиболее точные данные о состоянии пациента. При этом магнитно-резонансная томография максимально безопасна, и ее можно периодически проводить с целью отслеживания динамики лечения туберкулеза.
Компьютерная томография отличается большими возможностями при точном определении формы туберкулеза. МРТ отлично показывает себя, когда нужно конкретизировать диагноз и установить, что симптомы не вызваны другими видами болезней.
Стоит также помнить о том, что туберкулез может поражать не только легкие. Ему оказываются подвержены и другие внутренние органы - печень, костные структуры, мозг и другие. Использование современных методов диагностики направлено на то, чтобы установить локализацию основного поражения, понять, насколько тяжело протекает процесс.
В этом материале мы рассмотрим, чем поможет МРТ при диагностировании туберкулеза, чем отличается этот метод.
Симптомы туберкулеза
Существует большое количество различных признаков того, что организм человека оказался поражен туберкулезом. Но рекомендацию о прохождении МРТ выдает врач. Именно он скажет, какой орган нужно обследовать, требуется ли использовать дополнительное контрастное усиление.
Среди основных признаков заражения туберкулезом есть такие, как:
- Длительный сильный кашель, который не удается побороть различными лекарственными средства.
- Одышка даже в том случае, если для этого нет никаких особых предпосылок.
- Сильные боли в области груди, которые могут значительно усиливаться во время кашля, практически любой физической нагрузки или обычного дыхания.
- Лихорадка, общее ослабленное состояние, подъем температуры тела.
Предварительные методы диагностики
Описанные выше проявления могут сопровождать и другие виды заболеваний. Потому очень большое значение имеет применение дифференциальной диагностики.
В случае с туберкулезом, используется несколько основных средств:
- Флюорография.
- Бактериальный посев мокроты для поиска возбудителя болезни.
- Сбор пробы Манту.
- Диаскинтест.
Применение комплекса анализов, сбор мокроты, крови и мочи помогает установить, что у пациента действительно развивается туберкулез.
После того, как анализы дали положительный результат, можно использовать МРТ. Оно помогает установить локализацию очагов поражения, а также проверить состояние других внутренних органов.
Для чего используется МРТ при туберкулезе
Медики рекомендуют использовать такое средство диагностики специально для того, чтобы добиться нескольких основных результатов:
- Отслеживание локализации поражения организма в процессе туберкулеза.
- Степень распространенности паталогических изменений, установление единичного или множественных очагов.
- Степень тяжести протекания заболевания - одно или двухсторонний характер течения, наличие изменений диффузного характера.
- Конкретизация фазы заболевания.
Также магнитно-резонансная томография оказывается одним из наиболее эффективных средств в том случае, если нужно установить вид туберкулеза у пациента.
Цели проведения МРТ при туберкулезе
Существует сразу несколько целей выполнения магнитной томографии:
- Диагностика на ранних стадиях развития заболевания. Магнитно-резонансная томография позволяет понять, что пациент болен, пока инфекция не получила большого распространения и не успела нанести организму сильный вред.
- Выбор правильного лечения. Врачи могут отслеживать результаты лечения, а также своевременно корректировать его, чтобы добиться повышенной эффективности.
Многие врачи отмечают, что периодическое проведение обследований на аппарате МРТ позволяет избежать появления рецидивов. Таким образом, здоровье пациента оказывается под контролем.
Наш оператор перезвонит вам в течении 20 мин
Особенности проведения МРТ при туберкулезе легких
МРТ может проводиться как по назначению врача, так и по личной инициативе пациента. При этом направление врача позволит понять, какой формат обследования нужно проводить, стоит ли использовать дополнительное контрастное усиление.
Сам процесс стандартен для магнитно-резонансной томографии. Пациенту нужно прибыть на обследование точно в назначенное время. Далее вы ложитесь на кушетку, которая помещается внутрь томографа. Остается только сохранять полную неподвижность на протяжении всего времени процедуры, а также выполнять требования врача.
По результатам диагностики, врач составит подробное заключение. Данные можно будет использовать как при постановке диагноза, так и в процессе дальнейшего лечения.
Особенности отображения туберкулеза на МРТ-снимке
Рентгенолог делает выводы о том, что у человека туберкулез на основании просмотра снимков, а также изучения проработанной трехмерной модели, которая была создана томографом.
Основной признак туберкулеза на снимке - заметные уплотнения ткани легкого. Они могут быть как единичными, так и множественными. Основная область расположения - рядом с бронхами.
Также о заболевании говорит заметное увеличение лимфатических узлов. Конечный диагноз может поставить только врач.
Какие формы туберкулеза выявляет МРТ
Существует большое количество форм туберкулеза, которые можно определить с использованием магнитно-резонансной томографии. Но медики выделяют две основные:
- Первичная. Обычно заражение проводится еще в детском возрасте. При этом, есть вероятность того, что при попадании в организм человека возбудителя заболевания болезнь проявит себя либо как поражение лимфоузлов, либо как туберкулез.
- Вторичный. Запускается в том случае, если первичное заболевание дает рецидив, запускаются его остаточные явления. Есть большое количество видов вторичной формы - это милиарный, диссеминированный, очаговый, инфильтративный, каверзный и другие варианты туберкулеза.
Применение МРТ доказало свою результативность при диагностировании всех перечисленных форм заболевания.
Преимущества использования МРТ при диагностике туберкулеза
Метод магнитно-резонансной томографии рекомендуется при диагностике туберкулеза по целому списку причин. К ним относятся такие, как:
- Максимальная информативность. МРТ использует технологию создания множества мелких виртуальных срезов и формирования их них проработанной модели обследуемой области.
- Отсутствие боли и дискомфорта. Метод неинвазивный. Все что нужно пациенту - лечь на кушетку и не двигаться на протяжении всего времени обследования.
- Безопасность. В процессе обследования не оказывается никакого облучения и вредного воздействия на организм. Можно проводить обследование даже для детей и беременных женщин.
- Возможность многократного обследования. Можно выполнять МРТ для того, чтобы отслеживать результативность лечения, своевременно его корректировать.
Проведение МРТ доступно для большинства категорий пациентов. Вы получите максимально подробные результаты с минимальными затратами времени.

Что лучше - МРТ или КТ головного мозга
Рассмотрим, чем отличается КТ от МРТ головного мозга, ответим на вопрос, что безопаснее и результативнее.…

Противопоказания к МРТ позвоночника
В этой статье мы расскажем о том, какие есть противопоказания к МРТ позвоночника. При этом сразу подчеркнем,…

МРТ почек - подготовка к исследованию, как делают
Расскажем о том, как делают МРТ почек, когда и кому стоит обращаться для выполнения такого варианта диагностики.…
МРТ при туберкулезе

Снимок грудной клетки
Туберкулез - опасное заболевание, которое при несвоевременной диагностике имеет неблагоприятный прогноз. Раннее обследование патологий легких играет важную роль в проведении эффективного лечения. Первым методом, к которому прибегают врачи при подозрении на туберкулез легких или при профилактических осмотрах, является рентгенография.
Компьютерную и магнитно-резонансную томографию используют в качестве дополнительных вариантов обследования для определения расположения патологического очага, его размера и степени воспалительного процесса. Сравнивая КТ и МРТ, первый способ диагностики обладает более широкими возможностями выявления любых форм туберкулеза. МРТ при вышеупомянутом заболевании легких помогает дифференцировать патологию от других недугов: злокачественной и доброкачественной опухолей, воспалительных, паразитарных патологий и пр.
Палочка Коха, вызывающая туберкулез, может быть обнаружена в разных мягкотканных органах (печени, почках, мозге и др.) и костных структурах. Только при комплексной диагностике проводят дифференциацию патологии от других заболеваний, определяют степень, локализацию и тяжесть патологического процесса.
Клинические проявления разных болезней легких сходны. Основные симптомы, указывающие на необходимость комплексного обследования следующие:
- затяжной кашель;
- одышка;
- боль в области груди, усиливающаяся при кашле, дыхании, физической нагрузке;
- лихорадочное состояние;
- общая слабость и пр.
Первоочередным в дифференциальной диагностике туберкулеза является прохождение флюорографии, пробы Манту, Диаскинтест, бакпосев мокроты на Микобактерии возбудителя заболевания. При сомнительных результатах вышеуказанных обследований, наличии положительных реакций анализов, характерных изменений в составе крови, мочи, мокроты, визуализации патологии в легких на рентгеновском снимке, показана компьютерная или МР-томография легких. Благодаря послойному сканированию интересующей области удается получить детальное изображение органа, обнаружить патологические очаги, определить границы и объем поражения.
Делают ли МРТ легких при туберкулезе?
Для того, чтобы получить полную картину заболевания, прибегают к дополнительным методам диагностики. МРТ при туберкулезе делают значительно реже, чем КТ легких.
Туберкулез почки
Во время обследования с помощью МР- и КТ-томографа врачи определяют:
- распространенность изменений (один или множество очагов, полость, область инфильтрации и пр.);
- локализацию поражения (сегмент легких, диссеминация, системное распространение);
- тяжесть процесса (одно- или двухсторонний при локальных или диффузных изменениях);
- фазу развития заболевания (инфильтрацию, распад, обсеменение, уплотнение, рассасывание, кальцификацию);
- вид туберкулеза (первичный, вторичный, милиарный, кавернозный, опухолевый, инфильтративный и пр.)
МР-томография при туберкулезе играет важную роль при ранней диагностике изменений. Рутинный способ обследования пациентов не дает столь исчерпывающей информации о деталях течения патологического процесса. Отсутствие изменений в легких не означает отсутствия заражения. Следует продолжать поиски внелегочной формы туберкулеза при положительных результатах Манту или Диаскинтеста.
Благодаря магнитно-резонансной томографии при выявлении туберкулеза легких проводят:
- раннюю диагностику заболевания. Процедура помогает выявить малейшие изменения в органе до широкого распространения возбудителя инфекции. Важно определить патологию на начальной стадии туберкулеза - от этого зависит скорость выздоровления;
- корректировку лечения - с помощью обследования можно отследить динамику: прогресс или регресс заболевания. Данные визуализации позволяют судить об эффективности назначенной терапии;
- определение результативности - МРТ показывает отсутствие патологических признаков туберкулеза легких по окончанию лечения. При рентгенографии не удается определить мельчайшие очаги.
Прибегая к томографии, можно значительно сократить вероятность рецидива заболевания.
Как проходит МРТ при туберкулезе легких?
Предварительной подготовки процедура не требует. Пациент проходит в специальную комнату, где расположен томограф, ложится на стол. Аппарат оснащен датчиками, которые улавливают отклик тканей организма на воздействие магнитного поля.

Магнитно-резонансный томограф
Лаборант во время процедуры наблюдает за процессом из соседнего помещения, при необходимости корректирует действия больного. Специальная программа обрабатывает фотоснимки интересующей области и выводит смоделированное изображение на монитор. Общая продолжительность исследования составляет до 30 минут. Процедура безболезненна и безопасна.
Как выглядит туберкулез на снимке МРТ?
Туберкулез на КТ, как и на МРТ, диагностируют по основным признакам заболевания. Чаще других во время процедуры визуализируют на снимках:
- уплотнение легочной ткани - один или несколько очагов поражения рядом с бронхами;
- увеличенные лимфоузлы у корня легкого и средостения.
Только врач может распознать патологические очаги и вынести советующий диагноз.
Существует несколько форм туберкулеза:
- первичный - заражение происходит почти всегда в детском возрасте, формируются единичные или множественные очаги гранулематозного воспаления вследствие проникновения возбудителя заболевания. Развивается первичный туберкулезный комплекс либо специфическое поражение внутригрудных лимфоузлов. Оба варианта определяют при использовании методов визуализации. Первичный туберкулез может также протекать в форме туберкулезной интоксикации у детей, когда нет четкой локализации процесса и не формируется гранулём с казеозным некрозом;
- вторичный - возникает вследствие активации скрытых (остаточных) явлений первичной формы заболевания. Характерно распространение на лимфоузлы и бронхи, выход за пределы дыхательной системы. Выделяют несколько форм:
- милиарный туберкулез характеризуется множественными очагами поражения (до 2 мм), локализованными во всех сегментах легких, часто обнаруживают патологии в печени, почках, кишечнике, селезенке, мозге, костях. Данный вид заболевания имеет неблагоприятный прогноз и высокую скорость прогрессии. Поэтому важна ранняя диагностика.
![Туберкулез на снимке МРТ]()
Туберкулез на снимке МРТ (стрелками показаны очаги в паренхиме легких (а) и туберкулезный плеврит (b))
- диссеминированная форма туберкулеза представлена множественными очагами, которые могут иметь разную форму, в том числе однородную правильную. На снимках МРТ наблюдают распространенность патологических признаков по всем отделам легких;
- очаговый туберкулез локализован чаще в одном сегменте или доле. Поражение визуализируют в области бронхов и в междольковых перегородках. Размер очагов не превышает 1 см. Исходя из однородности структуры последних, врач делает вывод о давности процесса: при повышенной плотности заболевание существует длительное время;
- инфильтративный туберкулез на МР-томографии характеризуется уплотнением легочной ткани с формированием полости, заполненной жидкостью в центре;
- туберкулёма - образование, которое имеет плотную стенку, размером больше 1 см. Расположено чаще в верхних долях легкого. Для данной формы заболевания характерна неоднородность структуры очагов. На снимках могут быть обнаружены мягкотканные компоненты или поражения с включением кальция;
- при кавернозном туберкулезе визуализируют гладкие полости размером 2-3 мм (каверны). В структуре последних часто выявляют содержимое (при не функционирующем дренирующем бронхе). При фиброзной форме туберкулём определяют измененную ткань легкого вокруг каверны по буллезно-фиброзному типу, т.е. с формированием воздушных пузырей и рубцов;
- цирротический вариант заболевания возникает как следствие инфильтративного или кавернозного типов патологии. На снимках МРТ наблюдают буллезные очаги (воздушные полости), выраженные склеротические (рубцовые) изменения пораженных областей легкого, смещение средостения в сторону участка расположения патологического процесса;
- туберкулезный плеврит - на изображениях обнаруживают жидкость в грудном отделе, которая часто не отличается от нормального секрета.
- скрытый туберкулез. У пациента туберкулезная инфекция, но бактерии в организме неактивны и не вызывают никаких симптомов. Латентный туберкулез, также называемый неактивным или туберкулезной инфекцией, не заразен, но он может перейти в активную фазу, поэтому крайне важно провести необходимое лечение.
- активный туберкулез. Серьезное заболевание, которое в большинстве случаев может передаваться другим людям. Данное состояние может наступить через несколько недель или лет после заражения бактериями туберкулеза.
- кашель в течение 3 и более недель
- кашель с кровью или мокротой
- боль в груди, а также боль при дыхании или кашле
- непреднамеренная потеря веса
- усталость
- жар
- ночные поты
- озноб
- потеря аппетита.
- ВИЧ/СПИД
- диабет
- тяжелое заболевание почек
- некоторые виды рака
- лечение рака, например химиотерапия
- препараты для предотвращения отторжения трансплантированных органов
- некоторые препараты, используемые для лечения ревматоидного артрита, болезни Крона и псориаза.
- недоедание или низкая масса тела
- очень молодой или преклонный возраст
- употребление наркотиков. Внутривенные наркотики или чрезмерное употребление алкоголя ослабляют иммунную систему и делают пациента более уязвимым к туберкулезу
- табакокурение. Употребление табака значительно увеличивает риск заболеть туберкулезом и умереть от него
- работа в сфере здравоохранения. Регулярный контакт с больными повышает вероятность контакта с бактериями туберкулеза. Ношение маски и частое мытье рук значительно снижают риск
- проживание с больным туберкулезом. Тесный контакт с больным туберкулезом экстремально увеличивает риск заражения.
- спинальная боль. Боль в спине и скованность являются частыми осложнениями туберкулеза
- поражение суставов. Артрит, возникающий в результате туберкулеза (туберкулезный артрит), обычно поражает бедра и колени
- отек оболочек, покрывающих головной мозг (менингит). Это осложнение может вызвать продолжительную или прерывную головную боль, которая длится неделями, и возможные психические изменения
- проблемы с печенью или почками. Печень и почки помогают фильтровать отходы и примеси из кровотока. Туберкулез этих органов может нарушать их функции
- сердечные расстройства. В редких случаях туберкулез может поражать ткани, окружающие сердце, вызывая воспаление и скопление жидкости, что может препятствовать эффективной работе сердца. Это состояние, называемое тампонадой сердца, может привести к летальному исходу.
Важное значение при диагностике туберкулеза занимает проведение комплекса исследований, который позволяет выявить наличие патологически изменённых клеток в ткани легкого и в трахеобронхиальном дереве. Только имея полное представление о тяжести заболевания, специалист сможет назначить эффективную схему лечения.
В медицинском центре «Магнит» проводят диагностику туберкулезного заболевания с помощью КТ и МРТ. Заключение с комментариями эксперта Вы получите спустя 15-60 минут. В результате обследования будет определено состояние легких, что позволит лечащему врачу выбрать правильное направление лечения.
КТ суставов что показывает
![КТ суставов что показывает]()
Компьютерная томография является современным видом аппаратной диагностики. Метод позволяет визуализировать внутренние структуры без инвазивных манипуляций. С помощью КТ суставов определяют патологии опорно-двигательной системы различной этиологии и генеза.
![Изменения головки большеберцовой кости на томограмме]()
Изменения головки большеберцовой кости на томограмме
Компьютерную диагностику осуществляют с помощью рентгеновского излучения. Ионизирующие потоки проходят сквозь тело человека. Пропускная способность разных участков зависит от строения анатомических структур. Кости и хрящи обладают высокой рентгеноконтрастностью, сканирование рыхлых суставных элементов менее результативно.
Для большей информативности при обследовании мягкотканных структур применяют контрастную компьютерную томографию. В кровеносное русло вводят «окрашивающий» препарат на основе йода. Вещество обладает высокой поглощающей способностью в отношении рентгена, позволяет визуализировать сосудистую сеть и оценить строение всех морфологических элементов сочленения.
Что покажет КТ суставов и костей?
В результате томографии получают монохромные изображения тонких срезов изучаемой зоны. В отличие от линейной рентгенографии, КТ костей и суставов позволяет рассмотреть сочленение в трех взаимно перпендикулярных проекциях. На томограммах отсутствуют тени и дефекты от расположенных рядом анатомических образований.
Изображения КТ дают информацию о плотности исследуемого вещества. Светлые пятна на фото соответствуют твердым структурам, затемнения - мягкотканным участкам.
![Компьютерная томография колена]()
Компьютерная томография колена
КТ костей и суставов позволяет оценить:
состояние связочного аппарата;
ширину суставной щели;
толщину и однородность хрящевых элементов сочленения;
конгруэнтность (соответствие) суставных поверхностей;
особенности кровоснабжения сочленения;
состояние мышечной ткани, клетчаточных пространств;
строение костных суставных элементов.
С помощью сканирования определяют функциональность сочленения, выясняют причины нарушений.
В диагностике заболеваний суставов КТ позволяет выявить:
воспалительные явления ревматоидной природы;
инородные тела в области суставной сумки;
переломы костных суставных поверхностей;
Признаками патологии являются:
наличие в полости сустава крови, серозного или гнойного экссудата;
изменение ширины суставной щели;
нарушение целостности костных, хрящевых элементов сочленения;
смещение суставных поверхностей относительно друг друга;
синовиальные пролиферативные процессы;
наличие в костной ткани очагов с повышенной (остеосклероз) или пониженной (остеопороз) плотностью;
деформация суставных поверхностей;
снижение высоты хрящевых элементов;
нарушение кровоснабжения сочленения;
структурные изменения суставных элементов.
КТ показывает воспалительные, онкологические, дегенеративно-дистрофические явления, травматические повреждения костей и хрящей.
Контрастная томография помогает диагностировать добро- и злокачественные новообразования в области сочленения. По томограммам можно отследить динамику насыщения тканей опухоли «окрашивающим» раствором. Малигнизированные образования имеют патологически извитую сосудистую сеть с большим количеством анастомозов, что увеличивает время накопления и выведения контраста.
![Остеосаркома бедренной кости на снимке коленного сустава]()
Остеосаркома бедренной кости на снимке коленного сустава
Для уточнения локализации и размеров патологического очага врач может использовать пространственное изображение области интереса . На основании фотографий, полученных в результате сканирования, реконструируют 3D-модель рассматриваемой зоны. Трехмерная визуализация позволяет оценить характер взаимодействия здоровых и пораженных тканей.
Какие суставы исследуют при помощи компьютерной томографии
КТ позволяет детально изучить строение опорно-двигательной системы. Данный вид инструментальной диагностики является наиболее информативным при исследовании скелета человека.
КТ плеча
Сканирование назначают при жалобах пациента на боль и ограничение подвижности пояса верхних конечностей. При травмах КТ плечевого сустава позволит выявить повреждение головки одноименной кости, ключицы, лопатки.
Широкая амплитуда движений приводит к вывихам, разрывам связок, мышц, интраартикулярных (расположенных в полости сочленения) элементов. Компьютерная томография позволяет диагностировать травматические поражения и предупредить развитие осложнений.
КТ лучезапястного сустава
Анатомически сложное соединение с большим количеством мелких элементов затрудняет диагностику травм и патологических процессов. КТ лучезапястного сустава назначают при недостаточной эффективности других видов аппаратного исследования (УЗИ, рентген и пр.).
С помощью томографии диагностируют специфические заболевания:
асептический некроз полулунной кости (синдром Кинбека);
При травмах наблюдаются разрывы сухожилий и мышц запястья. Часто выявляют трещины и переломы лучевой кости.
КТ тазобедренного сустава
Боли в области сочленения возникают при патологических изменениях пара- (расположенных рядом) и интраартикулярных структур. К внутренним факторам относят:
поражение вертлужной впадины и бедренной кости;
пролиферативные нарушения синовиальной оболочки;
дегенеративные поражения хряща и пр.
![Трехмерная реконструкция тазобедренных сочленений]()
Трехмерная реконструкция тазобедренных сочленений
Внесуставные причины появления болей:
поражение крестцово-подвздошного и лонного сочленений;
КТ тазобедренного сустава используют для дифференциальной диагностики заболеваний, установления причины и характера патологического процесса.
КТ колена
С помощью компьютерной томографии визуализируют нарушения связочного аппарата, костных суставных поверхностей, гиалинового хряща, синовиальной оболочки и капсулы сочленения. Ограничение подвижности и боль возникают чаще при травмах, воспалительных и дегенеративных патологиях.
КТ коленного сустава позволяет диагностировать хондромаляции (разрушение хряща), повреждения менисков, разрывы крестообразных связок. В результате контрастной процедуры выявляют онкологические процессы, заболевания сосудов, липоартрит и пр.
КТ голеностопа
Сочленение представляет собой комбинацию небольших суставов, что служит причиной частой травматизации интраартикулярных анатомических образований. Компьютерная томография визуализирует состояние костных элементов малого размера, помогает выявить незначительные нарушения формы, величины, целостности анатомических структур.
КТ голеностопного сустава используют в диагностике новообразований, комбинированных патологий, когда процесс затрагивает твердые и мягкие ткани. Высокая точность снимков и возможность пространственной визуализации повышают эффективность компьютерной томографии в исследовании анатомически сложных сочленений.
КТ стопы и кисти
Суставы плюсны, ладони, пальцев рук и ног отличаются незначительными размерами и большим количеством мелких морфологических элементов.
На основании КТ стопы выявляют воспалительные, деструктивные, травматические поражения. Отмечают патологическое расположение костей плюсны и предплюсны при поперечном плоскостопии, вальгусной деформации и пр.
Исследование кисти помогает в диагностике ревматоидных поражений. Контрастная томография визуализирует сосудистые заболевания и неопластические процессы в области пясти и пальцев руки.
Как проходит КТ суставов?
Процедуру проводят с помощью сложного оборудования. Томограф представлен:
сканирующим комплексом, включающим рентгеновские излучатели и детекторы.
![Томограф Siemens]()
В процессе обследования происходят поступательное движение стола и вращение внутри кольца рентгеновских трубок и датчиков. Современные томографы за один оборот производят несколько снимков (2, 8, 16 и более). Мультиспиральная КТ суставов (МСКТ) обеспечивает высокую точность визуализации и позволяет снизить лучевую нагрузку на организм пациента.
Процедуру проводят в положении лежа. Пациент располагается на столе, врач проводит иммобилизацию конечностей для сохранения начальной позы. Непроизвольные движения негативно влияют на результаты исследования. Стол с пациентом начинает перемещаться внутри кольца томографа. Продолжительность нативного КТ-сканирования суставов 5-10 минут.
Медицинский персонал во время сеанса находится в соседнем помещении. Связь с обследуемым поддерживают через микрофон. Больному важно соблюдать рекомендации специалиста, возможно, потребуется изменение положения тела по команде врача. Динамическое сканирование проводят с целью определения функциональности суставов.
КТ кисти, стопы, лучезапястных и других небольших анатомических соединений можно проводить в положении сидя, для чего используют специальные аппараты.
Для достоверной оценки состояния одного из парных сочленений чаще рекомендуют сделать КТ обоих суставов.
При использовании контраста продолжительность исследования увеличивается на 10 минут. После серии нативных снимков больному вводят йодсодержащий раствор. Сканирование продолжают после заполнения препаратом сосудистого русла в рассматриваемой зоне.
![Артрозо-артрит голеностопа]()
Артрозо-артрит голеностопа, 3D-модель
Подготовка к компьютерной томографии сустава
Пациент приходит на прием за 10-15 минут до назначенного времени. Перед процедурой необходимо заполнить документы, снять украшения, аксессуары.
Контрастная КТ сустава требует более тщательной подготовки. Пациенты, страдающие сахарным диабетом и принимающие Метформин, посещают эндокринолога. Лекарственный препарат следует отменить за 72 часа до введения йодсодержащего раствора.
Для предупреждения развития осложнений со стороны органов фильтрации необходимо сдать анализ крови на креатинин. Повышенный уровень последнего свидетельствует о почечной недостаточности и является противопоказанием к использованию контрастного усиления.
Что выбрать: рентген, МРТ или КТ суставов?
Выбор способа аппаратного исследования зависит от дифференциально-диагностических задач, клинической картины, наличия противопоказаний и других факторов.
Что показывает КТ грудной клетки, подготовка, показания и противопоказания
![КТ грудной клетки фото]()
КТ органов грудной клетки - усовершенствованный способ рентгенографической визуализации, который использует излучение для создания детальных изображений грудины, грудино-ключичных суставов, ребер, прилежащих мягких тканей и органов (в первую очередь, легких).
Исследование проводят, если после выполненной обычной рентгенографии причина жалоб осталась неясной или есть подозрение на патологический процесс в данной области. Компьютерная томография органов грудной клетки может быть выполнена в качестве альтернативы МРТ, если у пациента есть противопоказания к проведению магнитно-резонансного сканирования. Для лучшей визуализации возможно введение контрастного вещества. Основным преимуществом КТ является его способность одновременно демонстрировать кости, мягкие ткани (при контрастировании) и кровеносные сосуды.Что показывает КТ грудной клетки
![Мультиспиральная КТ грудной клетки, 3D-реконструкция]()
Мультиспиральная КТ грудной клетки, 3D-реконструкция
Специалисты выделяют в средостении три области: центральное (сосудистое пространство с перикардом и его содержимым, сосудами и лимфатическими узлами), переднее (жировая клетчатка, вилочковая железа, внутренние грудные артерии и лимфоидные ткани) и заднее (трахея, пищевод, нисходящая часть грудной аорты, лимфоузлы и паравертебральные пространства грудной клетки). Соответственно, все патологические процессы, которые протекают в данных зонах, могут быть видны.
Грудина, ребра и их сочленения - основные структуры передней стенки грудной клетки - подвержены различным анатомическим аномалиям и патологическим процессам, которые в некоторых случаях требуют лечения. Врач обосновано направит на диагностическую процедуру, если у пациента имеет место необъяснимый длительный кашель, загрудинные боли, кровохарканье, увеличение регионарных лимфоузлов, ограничение в движении плеча, скованность в области грудного отдела позвоночника и др. КТ органов грудной клетки и средостения может показать следующие изменения:
Остеоартроз (остеоартрит) - распространенная патология, затрагивающая чаще грудино-ключичные суставы. На компьютерной томограмме, в отличие от рентгенограммы, можно увидеть субхондральный склероз, кисты, сужение суставной щели и изменения в волокнистой хрящевой ткани диска. Серонегативные артриты, подагра и некоторые иные заболевания также могут затрагивать соединения отделов грудины между собой и с окружающими костными структурами, что убедительно видно на КТ.
Ранняя диагностика септического артрита грудино-ключичного сустава важна для своевременного начала лечения, так как существует высокий риск осложнений - целлюлита, остеомиелита, медиастинита, септического шока. В запущенных случаях можно увидеть абсцесс и формирование свищевого хода. Изменения, которые видны при КТ органов грудной клетки, включают воспалительные процессы в твердых структурах (разрушение суставных поверхностей, расширение суставной щели), в органах и тканях (диффузная инфильтрация, скопление жидкости, газа, размытость границ, реактивное увеличение лимфоузлов). Осложнившуюся пневмонию, плеврит, абсцесс легкого и мягких тканей грудной клетки можно диагностировать с помощью КТ. Исследование также показывает изменения со стороны сердца и клапанного аппарата.
Острые и травматические состояния.
В результате сильного физического воздействия (чаще - вследствие ДТП) возникают один или несколько переломов грудины. Компьютерная томография позволяет диагностировать сочетанные травмы (повреждения ребер, грудного отдела позвоночника, легких и сердца) и осложнения (легочные ателектазы, гемо- и пневмоторакс, гемоперикард). Спонтанные переломы грудины возникают при наличии новообразования (множественная миелома, метастазирование), остеопороза и могут имитировать острые коронарные заболевания. С помощью КТ грудной клетки возможна диагностика врожденных аномалий сосудов или приобретенных патологий: тромбоэмболии легочной артерии, диссекции аорты и пр. По данным КТ ОГК выявляют причины ишемии, дисфункцию сердечных клапанов.
После выполнения стернотомии (операция обеспечивает лучший доступ к сердцу) есть вероятность осложнений: расхождения краев раны, вторичный остеомиелит грудины или ребер, медиастинит и медиастинальная гематома, плевральный выпот. После хирургических вмешательств на сердце и сосудах могут развиться неблагоприятные последствия (инфицирование электродов кардиостимулятора, инфекционно-воспалительные осложнения и пр.). Эти состояния с помощью КТ дифференцируют с нормальными послеоперационными изменениями. У таких пациентов выполняют компьютерное сканирование в динамике. Осложнения могут присутствовать и после вмешательств на легких и прочих структурах. В экстренных ситуациях преимущество КТ - быстрота получения результатов.
Новообразования и метастазирование.
Большинство неопластических процессов грудины носит метастатический характер, что объясняется прямым проникновением из соседних органов или гематогенным путем. Рак молочной и щитовидной желез, легкого, почки, толстой кишки и лимфомы - самые распространенные источники метастазов грудины. КТ грудной клетки с контрастом - золотой стандарт в диагностике рака легких, позволяет увидеть изменения на начальной стадии, при которой возможно радикальное лечение. Компьютерное сканирование показывает также новообразования средостения, которые многообразны по морфологии и генезу. Наиболее часто встречаются тимомы, кисты, нейрогенные опухоли, злокачественные лимфомы. С помощью сканирования при дисфагии можно предположить рак пищевода, но во всех случаях окнчательный диагноз подтверждает морфологическое исследование.
Нередко пациенты задают вопрос: “Что сделать - КТ или МРТ органов грудной клетки?” К каждому исследованию есть свои показания и противопоказания, но способы часто являются взаимодополняющими. Специалисты диагностического центра могут подсказать, что предпочтительнее в каждом конкретном случае, но лучше, если на руках будет направление от лечащего врача.
Как делают КТ органов грудной клетки
![Положение пациента во время КТ грудной клетки]()
Положение пациента во время КТ грудной клетки
На диагностическую процедуру необходимо предварительно записаться, но возможно выполнение в день обращения, по жизненным показаниям. Современные КТ-сканеры могут исследовать большие участки тела всего за несколько секунд, что особенно подходит для пациентов, испытывающих трудности с длительной неподвижностью и маленьких детей. Рентген-техник размещает пациента на столе, для обеспечения неподвижности возможно использование фиксирующих ремней и подушек. Излишняя мобильность приводит к появлению размытости на изображениях. Наблюдение за ходом процедуры ведется из смежного кабинета, через стекло. Для экстренных случаев есть кнопка связи с персоналом. Стол с пациентом скользит вглубь томографа, вокруг тела начинает вращаться множество рентгеновских датчиков, передавая изображения поперечного сечения грудной клетки на экран монитора. Снимки с помощью специальной компьютерной программы могут быть переформатированы в другие плоскости. Полученные в результате диагностики данные легко перенести на любой носитель или распечатать. Неприятных ощущений во время КТ органов грудной клетки и средостения нет, технический шум, который производит работающее оборудование, можно нивелировать, если воспользоваться наушниками. Сканирование длится менее минуты, вся процедура с подготовкой и укладкой занимает не более получаса.
Для улучшения визуализации в некоторых случаях (преимущественно, в диагностике злокачественных новообразований и для оценки динамики после проведения химиолучевой терапии) выполняют КТ органов грудной клетки с контрастом. Препарат вводят внутривенно, перед этим обязательно оценивают уровень креатинина в крови. Усиленная радиофармпрепаратом компьютерная томография помогает уточнить диагноз при туберкулезе (количество очагов, их расположение, состояние лимфоузлов), но окончательная верификация происходит после оценки результатов комплексного обследования (пробы Манту, диаскинтеста, и, при необходимости, биопсии). Воспаление и повреждение паренхимы легких обычно хорошо видны на КТ без контрастного усиления. Если есть опасения по поводу осложнений, радиофармпрепарат может помочь дополнительно определить степень выраженности патологического процесса.
КТ органов грудной клетки детям проводят исключительно по жизненным показаниям в специальных диагностических центрах при педиатрических клиниках.
Подготовка к исследованию
![Перед прохождением диагностики убедитесь в отсутствии противопоказаний]()
Перед прохождением диагностики убедитесь в отсутствии противопоказаний
Каких-либо длительных мероприятий подготовка к КТ грудины не подразумевает, для нативного исследования достаточно выбрать удобную одежду без металла, снять украшения. Если предстоит введение контрастного вещества, за 40-50 минут до начала процедуры необходимо неплотно перекусить, что поможет предотвратить или уменьшить вегетативные реакции (легкую тошноту, слюнотечение, головокружение). Пациенты, страдающие сахарным диабетом и принимающие Метформин, по согласованию с эндокринологом должны отказаться от препарата за 48 часов до процедуры. Во время лактации рекомендуют сделать запас молока на два кормления.
Показания и противопоказания к КТ грудины
КТ грудины входит в компьютерное сканирование грудной клетки. Диагностика не является рутинным методом обследования и выполняется, если причина заболевания остается неясной или изменения на рентгенограммах требуют уточнения.
Перечислим основные показания к КТ грудины и грудной клетки:
подозрение на патологический процесс в легких, плевре, сердце, грудине, суставах, средостении;
пред- и послеоперационное обследование;
определение зоны для лучевого воздействия при злокачественных новообразованиях соответствующей области;
отслеживание динамики после проведенного лечения.
Противопоказания к КТ грудины и грудной полости
Современная аппаратура позволяет минимизировать лучевую нагрузку по сравнению с обычной рентгенографией в 1,5-2 раза: КТ ОГК безопасна для большинства людей. Исключение - беременные женщины и дети в возрасте до 14 лет. По техническим причинам диагностическая процедура невыполнима у пациентов с выраженным ожирением (выше 150 кг).
Противопоказания к выполнению контрастирования:
хроническая почечная недостаточность с повышением уровня креатинина;
Введение индикаторного препарата недопустимо, если во время или после предыдущего контрастирования развилась серьезная реакция гиперчувствительности по типу отека Квинке или анафилаксии. Небольшая тошнота, металлический привкус, головокружение, приливы жара рассматриваются как вариант нормы и не являются противопоказаниями к КТ с усилением.
Фото томографии грудной клетки
Расшифровка снимков происходит в тот же день. Полученные изображения анализирует врач-рентгенолог, который и выдает заключение. Определить верный диагноз непросто, ведь среди нескольких десятков оттенков черного, серого и белого необходимо вычленить несоответствующий норме и интерпретировать результат. Представим Вашему вниманию несколько фото томографии грудной клетки:
![Перед прохождением диагностики убедитесь в отсутствии противопоказаний]()
КТ без контраста у пациента с интерстициальным заболеванием легких в анамнезе и трансплантацией правого легкого показывает суженный участок анастомоза правого бронха (красная стрелка). Собственное левое легкое уменьшено в размерах, с признаками бронхоэктазов, бронхиолоэктазов (черная стрелка). Сужение центрального дыхательного пути на выдохе у трансплантированного легкого (синяя стрелка).
![Выпот (красные стрелки) в обеих плевральных полостях.]()
Выпот (красные стрелки) в обеих плевральных полостях.
КТ или Рентгенография при туберкулезе легких - что покажет
![]()
КТ легких, рентгенография легких являются основными аппаратными методами диагностики туберкулеза легких. Исходя из первичных симптомов, истории болезни, противопоказаний и диагностических целей, врач фтизиатр назначает необходимые способы обследования. В большинстве случаев рентгенография легких выбирается как первичный метод диагностики. Если результаты исследования носят тревожный или неясный характер, дополнительно назначается КТ легких.
Туберкулез представляет собой потенциально серьезное инфекционное заболевание, поражающее преимущественно легкие. Бактерии, вызывающие туберкулез, передаются от человека к человеку через крошечные капельки, выделяемые в воздух при кашле и чихании. Многие штаммы туберкулеза устойчивы к препаратам, наиболее часто используемым для лечения этого заболевания. Пациенты с активным туберкулезом должны месяцами принимать различные препараты, чтобы избавиться от инфекции и предотвратить резистентность к антибиотикам.
Несмотря на то, что в организме пациента могут быть бактерии, вызывающие туберкулез, иммунная система обычно может предотвратить это заболевание. По этой причине заболевание подразделяется на следующие типы:
Симптомы активного туберкулеза:
Туберкулез также может поражать другие части тела, включая почки, позвоночник или головной мозг. Когда туберкулез возникает вне легких, симптомы различаются в зависимости от пораженных органов. Например, туберкулез позвоночника может вызвать боль в спине, а туберкулез почек может вызвать появление крови в моче. Следует незамедлительно обратиться к фтизиатру при появлении жара, необъяснимой потери веса, интенсивного ночного потоотделения или постоянного кашля. Данные симптомы очень часто сопровождают туберкулез, но они также могут быть следствием других заболеваний.
Причины туберкулеза
Туберкулез вызывается бактериями, которые передаются от человека к человеку через микроскопические капли, выделяемые в воздух. Это может произойти, когда пациент с невылеченной активной формой туберкулеза кашляет, говорит, чихает, плюется, смеется или просто говорит. Хотя туберкулез заразен, заразиться им непросто. Большинство пациентов с активным туберкулезом, прошедших соответствующую терапию в течение как минимум 2 недель, больше не заразны.
ВИЧ и туберкулез
ВИЧ подавляет иммунную систему, из-за чего организму трудно контролировать бактерии туберкулеза. В результате у пациентов с ВИЧ гораздо больше шансов заболеть туберкулезом и перейти от латентного заболевания к активному, чем у потенциальных пациентов, не инфицированных ВИЧ.
Лекарственно-устойчивый туберкулез
Туберкулез также остается главной причиной смерти из-за увеличения числа устойчивых к лекарствам штаммов. Со временем некоторые туберкулезные микробы научились выживать, несмотря на лекарства. Отчасти это связано с тем, что пациенты не принимают лекарства в соответствии с указаниями или не завершают курс лечения. Лекарственно-устойчивые штаммы туберкулеза появляются, когда антибиотик не может убить все бактерии, на которые он нацелен. Выжившие бактерии становятся устойчивыми к этому препарату, а часто и к другим антибиотикам. Некоторые туберкулезные бактерии выработали устойчивость к наиболее часто используемым методам лечения. У некоторых штаммов туберкулеза также развилась устойчивость к препаратам, редко используемым для лечения данного заболевания, таким как антибиотики и инъекционным препаратам. Эти лекарства часто используются для лечения инфекций, устойчивых к более распространенным препаратам.
Факторы риска
Любой человек может заболеть туберкулезом, но некоторые факторы могут увеличить риск заболевания. Здоровая иммунная система часто успешно борется с бактериями туберкулеза. Однако некоторые состояния и лекарства могут ослабить иммунную систему, в том числе:
Осложнения
Без лечения туберкулез может привести к летальному исходу. Невылеченное активное заболевание обычно поражает легкие, но может поражать и другие части тела. Основные осложнения туберкулеза:
Диагностика туберкулеза
Во время медицинского осмотра фтизиатр обследует лимфатические узлы на наличие отека и с помощью стетоскопа прослушает звуки, которые издают легкие при дыхании. Наиболее часто используемой и эффективной диагностической процедурой для выявления туберкулеза является кожная проба. Небольшое количество вещества, называемого туберкулином, вводится под кожу на внутренней стороне предплечья. В течение 48-72 часов фтизиатр проверит руку пациента на наличие отека в месте инъекции. Твердая выпуклая красная шишка означает вероятное наличие туберкулезной инфекции. Размер выпуклости определяет, являются ли результаты теста значимыми. Кожный тест на туберкулез не идеален. Иногда результат ошибочно предполагает туберкулез или его отсутствие. Ложноположительный результат может быть в том случае, если пациент недавно был вакцинирован бациллой Кальметта-Герена. Эта противотуберкулезная вакцина широко применяется в странах с высоким уровнем заболеваемости туберкулезом. Возможны и ложноотрицательные результаты.
Анализы крови могут подтвердить или исключить латентный или активный туберкулез, исследуя реакцию иммунной системы на бактерии туберкулеза. Анализ крови может быть актуален в случае высокого риска заражения туберкулезом при отрицательной реакции на кожный тест.
При положительном кожном тесте, фтизиатр назначает пациенту флюорографию грудной клетки, рентгенографию или компьютерную томографию. Данные процедуры могут выявить белые пятна в легких - области, где иммунная система оградила бактерии туберкулеза. Кроме того, будут выявлены конкретные изменения в легких, вызванные активным туберкулезом.
Если рентген грудной клетки выявил признаки туберкулеза, то врач может отобрать образцы мокроты — слизи, которая выделяется при кашле. Образцы исследуются на наличие бактерий туберкулеза. Образцы мокроты также можно использовать для тестирования на лекарственно-устойчивые штаммы туберкулеза. Это позволит врачу выбрать лекарства, которые с большей вероятностью окажут медикаментозный эффект. Получение результатов этих исследований может занять от 4 до 8 недель.
КТ или рентгенография при туберкулезе легких - что лучше выбрать?
Основными достоверными диагностическими критериями туберкулеза при поражении легких являются рентгенологическая картина и результат исследования мокроты. Н Мультиспиральная компьютерная томография и рентген легких являются основными формами аппаратной диагностики ТБ. Они относятся к классу рентгенографических обследований и используют свойство рентгеновских лучей по-разному проходить через ткани организма с разной плотностью. По степени затемнения того или иного участка рентгенолог может судить о состоянии органов грудной полости. Рентгенография дает возможность получить снимок в двух проекциях. КТ грудной клетки дает более точное трехмерное обследование по сравнению с рентгеном. Главное преимущество МСКТ органов перед другими рентгенографическими методами - это высокая точность и информативность. Благодаря тому, что источники излучения в современных томографах являются подвижными, рентгенолог получает целую серию послойных снимков, позволяющих разглядеть туберкулезные поражения легких. После компьютерной обработки томограф выстраивает на основании этих снимков трехмерное изображение обследуемой области, что тоже увеличивает информативность КТ при туберкулезе. Помимо состояния легких, томограмма позволяет оценить состояние кровеносной системы и лимфоузлов в обследуемой полости.
Рентгенография органов клетки является первичным методом диагностики туберкулеза. Ее данные позволяют установить факт болезни, провести дифференциальную диагностику туберкулеза от пневмонии, абсцесса и опухоли. Цифровая рентгенография позволяет определить характер поражения ткани легких (инфильтративный, очаговый, диссеминированный, кавернозный туберкулез) и локализацию очагов. Первичные признаки ТБ включают наличие очага или их группы в легких и увеличение лимфоузлов.
КТ ОГК используется как экспертный метод обследования и показывает изменения в легких, которые не видны на обычном рентгене или флюорографии из-за сравнительно низкой разрешающей способности, например, мелкие кальцинаты, бугорки и рубцы на легочной ткани. Данные компьютерной томографии также позволят провести более точную дифференциальную диагностику вида и стадии туберкулеза:
Читайте также:













